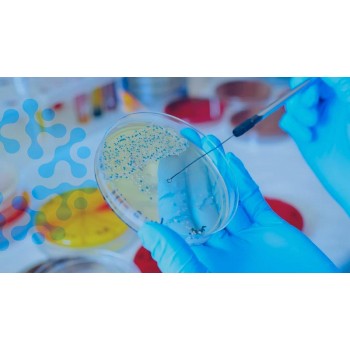

ATLAS PT' ye Hoşgeldiniz
ATLAS PT, 2023 yılında Uşak’ta, çevre laboratuvarı ve danışmanlık alanında deneyim kazanmış uzman bir ekip tarafından kurulmuş olup, Yeterlilik Testleri ve Laboratuvarlar arası karşılaştırma testleri gerçekleştirmek için gerekli altyapıyı oluşturmuş, ISO/IEC 17043 standardına uygun olarak akredite bir yeterlilik sağlayıcısıdır. Amacımız, laboratuvarların performanslarını en üst düzeye çıkarmalarına yardımcı olmak ve test hizmeti sunan kuruluşların analiz yeteneklerini güvenilir bir şekilde değerlendirerek güvenilirliklerini artırmaktır. Bu doğrultuda kapsamlı yeterlilik testleri sunuyoruz.
Alanında deneyimli ekibimizle, en yüksek kalite standartlarını sağlamak için sürekli olarak yenilik yapıyoruz. ATLAS PT, hizmet kapsamındaki YT programları için bilimsel temellere dayalı, önyargısız, hatasız ve profesyonel bir çalışma metodu uygulamaktadır. Ayrıca, hizmet kapsamını her geçen gün genişleterek sektördeki en iyi uygulamaları ve standartları benimsemekteyiz.
Müşterilerimizin ihtiyaçlarını karşılamak ve onlara destek olmak amacıyla yenilikçi çözümler geliştirmeye devam ediyoruz. Güven, kalite ve profesyonellik odaklı yaklaşımımızla, laboratuvarların performansını artırmak ve sektörde güvenilir bir referans olmak için kararlılıkla çalışıyoruz. ATLAS PT olarak, laboratuvar yeterlilik testleri alanında güvenilir ve sürekli gelişen bir çözüm ortağı olmayı hedefliyoruz.
Alanında deneyimli ekibimizle, en yüksek kalite standartlarını sağlamak için sürekli olarak yenilik yapıyoruz. ATLAS PT, hizmet kapsamındaki YT programları için bilimsel temellere dayalı, önyargısız, hatasız ve profesyonel bir çalışma metodu uygulamaktadır. Ayrıca, hizmet kapsamını her geçen gün genişleterek sektördeki en iyi uygulamaları ve standartları benimsemekteyiz.
Müşterilerimizin ihtiyaçlarını karşılamak ve onlara destek olmak amacıyla yenilikçi çözümler geliştirmeye devam ediyoruz. Güven, kalite ve profesyonellik odaklı yaklaşımımızla, laboratuvarların performansını artırmak ve sektörde güvenilir bir referans olmak için kararlılıkla çalışıyoruz. ATLAS PT olarak, laboratuvar yeterlilik testleri alanında güvenilir ve sürekli gelişen bir çözüm ortağı olmayı hedefliyoruz.
Yeterlilik Testi Nedir?
Yeterlilik testi, laboratuvarların ve test hizmeti sağlayıcılarının analitik ve ölçüm yeteneklerini değerlendirmek için düzenlenen sistematik bir süreçtir. Bu testler, laboratuvarların kendi performanslarını gözlemlemelerine ve geliştirmelerine olanak tanır. Yeterlilik testleri, uluslararası standartlar doğrultusunda yapılmakta ve katılımcılara çeşitli avantajlar sunmaktadır.
TÜM HİZMETLERİMİZ
Yeni Haber ve Duyurularımız
0
1
Değerli Laboratuvarlar,
Atlas PT Eğitim ve Danışmanlık Ltd. Şti. tarafından, ISO/IEC
17043, ISO 13528 ve TÜRKAK Yeterlilik Testleri Akreditasyon
Rehberi gerekliliklerine uygun olarak aşağıda belirtilen alanlarda Yeterlilik
Testi (YT) çevrimi düzenlenecektir.
Katılım sağlamak isteyen laboratuvarların belirtilen son
başvuru tarihine kadar başvurularını tamamlamaları önemle rica olunur.
Program Kodu
Matrix / Alan
Parametre(ler)
Son Başvuru
EMS-02-26-04..
0
1
Değerli Laboratuvarlar,
Atlas PT Eğitim ve Danışmanlık Ltd. Şti. tarafından, ISO/IEC
17043, ISO 13528 ve TÜRKAK Yeterlilik Testleri Akreditasyon
Rehberi gerekliliklerine uygun olarak aşağıda belirtilen alanlarda Yeterlilik
Testi (YT) çevrimi düzenlenecektir.
Katılım sağlamak isteyen laboratuvarların belirtilen son
başvuru tarihine kadar başvurularını tamamlamaları önemle rica olunur.
Program Kodu
Matrix / Alan
Parametre(ler)
Son Başvuru
EMS-0..
0
3
Değerli Laboratuvarlar,
Atlas PT Eğitim ve Danışmanlık Ltd. Şti. tarafından, ISO/IEC
17043, ISO 13528 ve TÜRKAK Yeterlilik Testleri Akreditasyon
Rehberi gerekliliklerine uygun olarak aşağıda belirtilen alanlarda Yeterlilik
Testi (YT) çevrimi düzenlenecektir.
Katılım sağlamak isteyen laboratuvarların belirtilen son
başvuru tarihine kadar başvurularını tamamlamaları önemle rica olunur.
Program Kodu
Matrix / Alan
Parametre(ler)
Son Başvuru
EMS-02-26-02..